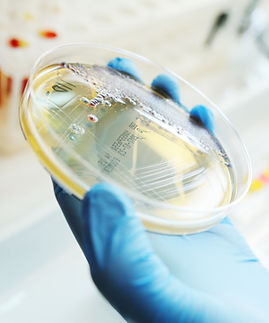
shutterstock_784635523 (1).jpg

cGMP Quality Compliance, Simplified.
Pharmalliance offers specialist support to Pharmaceutical, Medtech and Cosmetic companies to maintain and increase quality compliance levels.
We support clients through regulatory scrutiny, contamination events, operational challenges and complex projects by embedding compliance and contamination control from the beginning.
Want to Stay Updated?
Join our email list and get access to specials deals exclusive to our subscribers.
Global Aseptic CDMO
Senior Global Director QA
CCS in 6 weeks project
“The whole project was very professionally handled. The experience and knowledge of the Pharmalliance team was outstanding and helped much overcoming misunderstandings and knowledge gaps on our side. Deliverables were provided in time and Pharmalliance kept us on track.”
Sterile Ophthalmic CDMO
QA Remediation Lead
cGMP Remediation Project
“Pharmalliance delivered exactly what we needed – fast, relevant, and high-quality training tailored to our remediation project.
The content was precise and aligned with FDA and EMA expectations for Sterile Manufacturing. Their willingness to adapt the program made a real difference for our team.”
Irish OSD CDMO
Executive Project Lead
Drug Shortage Remediation
“Pharmalliance supplied a team of QA and Engineering specialists who assisted in an operation and quality excellence improvement project.
The result was a marked increase in throughput, which help eliminate a shortage of supply to the market, and a major drop in production downtime.”
Some of our happy clients


Trusted cGMP Expertise Across the Full Manufacturing Lifecycle
Manufacturing sites fail inspections and experience delays when compliance is treated as an afterthought. We take a different approach. We integrate cGMP compliance, contamination prevention and risk-based decision making into every stage of the facility and operational lifecycle.
We support sterile, non-sterile, ATMP, oral solid dose and cosmetics operations across Ireland and globally. View our services below.
Address
Glasshouses G2,92 George's Street LowerDún Laoghaire, Dublin, A96 VR66, Ireland
Phone
+353 (0)1 969 2000

.jpg)





